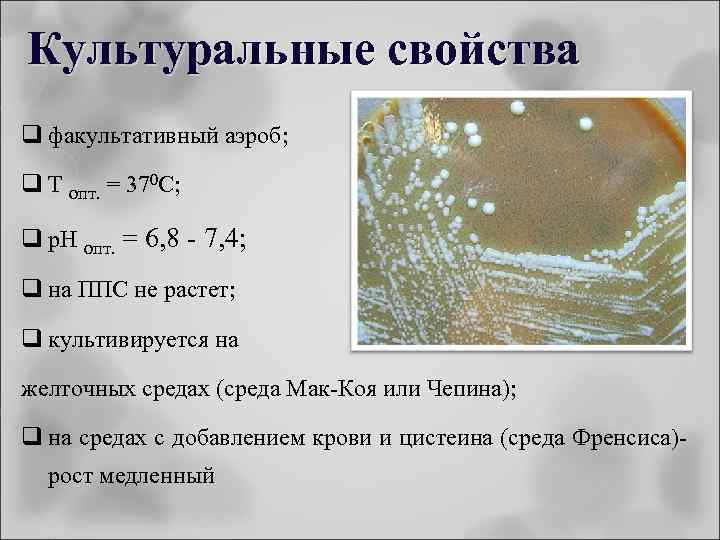
Культуральные свойства q факультативный аэроб; q Т опт. = 370 С; q p. H

Возбудители ООИ. Туляремия. Бруцеллез..ppt
- Количество слайдов: 45

ФГБОУ ВПО «Ивановская государственная медицинская академия» Минздрава России Кафедра микробиологии и вирусологии Возбудители особо опасных инфекций Туляремия, бруцеллез д. б. н. , проф. Кузнецов О. Ю. © 2016

Возбудитель туляремии - Francisella tularensis род Francisella - семейство Brucellacea F. tularensis и F. Francisuola (у животных). • был открыт в 1911 г. Мак-Коем и Чепиным в США в районе калифорнийского озера Туляре; позднее изучен Э. Френсисом – в честь его и название Франциселла, а туляремия - в честь местечка Туляре, где впервые обнаружено заболевание; • резервуар - многие виды преимущественно мелких диких позвоночных животных (мышевидных, заячьих, беличьих и тушканчиковых); • на территории России основными носителями являются мышевидные грызуны - водяные крысы, ондатры, различные виды полевок; • переносчики – кровососущие членистоногие (клещи, блохи, слепни, комары)

Морфология q Гр – палочки; q очень мелкие (0, 3 -0, 5 мкм); q полиморфные; q неподвижные; q спор не образуют; q могут образовывать капсулу
Культуральные свойства q факультативный аэроб; q Т опт. = 370 С; q p. H опт. = 6, 8 - 7, 4; q на ППС не растет; q культивируется на желточных средах (среда Мак-Коя или Чепина); q на средах с добавлением крови и цистеина (среда Френсиса)рост медленный

Культуральные свойства – рост в виде пленки; q на жидких средах q на плотных средах - образует мелкие молочно-белые колонии «капельки росы» , круглые с ровным краем, выпуклые, блестящие, с голубоватым отливом; q хорошо культивируется в желточном мешке куриного эмбриона; q в ферментативном отношении не активны; q б/х активность низкая: слабо ферментируют до кислоты без газа некоторые углеводы (глюкозу, мальтозу, левулёзу, маннозу), образуют сероводород

Антигенная структура q О – Аг - глюцидопептидный комплекс (сходен с ОАг бруцелл); q Vi – Аг - (капсульный) на поверхности (2 агента с протективными свойствами); • диссоциация S R приводит к утрате капсулы, вирулентности и иммуногенности; • Различают 3 подвида: Американская разновидность, Европейская и Среднеазиатская

Вирулентность обусловлена: q капсулой (угнетающей фагоцитоз); q нейраминидазой (способствующей адгезии); q эндотоксином (интоксикация); q аллергенными свойствами клеточной стенки; q способностью размножаться в подавлять их киллерный эффект; фагоцитах и q наличием рецепторов к Fc- фрагменту Ig. G; q способностью подавлять комплемента и макрофагов активность систем

Эпидемиология туляремии q природно-очаговое заболевание; q источник - чаще всего мелкие грызуны (полевые мыши, водяные крысы, ондатры, хомяки) и зайцы; q передача возбудителя через кровососущих членистоногих: иксодовые клещи, комары, в меньшей степени блохи, слепни и гамазовые клещи. q минимальная инфицирующая доза - одна микробная клетка; q Лухский, Пестяковский эндемичны по туляремии р-ны Ивановской обл.

Эпидемиология туляремии

Эпидемиология туляремии q. Туляремия - зоонозная болезнь; qпути передачи трансмиссивный, аспирационный (аэрозольный), контактнобытовой и алиментарный (пищевой); qотсутствие передачи инфекции от человека к человеку - биологический тупик !

Патогенез туляремии Гранулёмы q F. tularensis проникают через неповрежденную кожу и слизистые; q на месте внедрения (кожа, слизистые оболочки глаз, дых. путей, ЖКТ) развивается первичный воспалительный очаг; q возбудитель распространяется по л. сосудам и узлам; q образуются первичные бубоны; q в различных органах формируются гранулемы; q возбудитель и его токсины проникают в кровь; q бактериемия и генерализация процесса; Первичный бубон q развитие вторичных туляремийных бубонов

Проявления туляремии Первичный аффект в виде папулы, пустулы, из которых развиваются язвы с неровными краями и сероватым некротическим дном

Клиника туляремии q болезнь начинается внезапно, без продромального периода; q периодическое познабливание → подъём температуры тела до 38 -40°С (от 5 – 7 до 30 дней); q упорная головная боль, головокружение, мышечные боли, слабость, отсутствие аппетита; q лицо у больных гиперемировано, отёчно;


Клиника туляремии q раннее увеличение печени (со 2 -го дня), позже увеличивается селезенка (на 5 -8 -й день); q различают бубонную, язвенно-бубонную, глазобубонную, ангинозно-бубонную, абдоминальную (кишечную), лёгочную ц генерализованную (первично-септическую) клинические формы; q чаще встречается воспаление регионарных лимфатических узлов (бубон) – малоболезненен; q летальность до 5%

Больной ангинозно-бубонной формой туляремии: видны увеличенные подчелюстные лимфатические узлы Больной бубонной формой туляремии: в левой подмышечной впадине видны увеличенные лимфатические узлы.

Микробиологическая диагностика q материал для исследования: кровь, пунктат из бубона, соскоб из язвы, отделяемое конъюнктивы, налет из зева, мокрота и др. ; q основной метод – биологический (т. к. возбудитель растет медленно – 14 дней); q на первый план выступает аллергическая проба (с 3 -5 дня заболевания) и серодиагностика; Чистую культуру выделяют после накопления ее на восприимчивых лабораторных животных, из внутренних органов при посеве на желточную среду или заражая куриные эмбрионы в желточный мешок.

Микробиологическая диагностика Культуру идентифицируют по совокупности следующих признаков: а) морфология клеток и Гр- окраска; б) рост на желточной среде и специальных средах и отсутствие роста - на ППС; в) специфическое свечение в реакции иммунофлюоресценции; г) агглютинация культуры туляремийной сывороткой; д) способность вызывать гибель белых мышей и морских свинок с характерными патологоанатомическими изменениями в органах и выделением чистой культуры;

Микробиологическая диагностика q бактериологические методы диагностики носят дополнительное значение и не всегда эффективны, что объясняется малой концентрацией возбудителя в организме; q как метод выявления туляремийного микроба используется МФА, реакция нейтрализация антител - РНАТ, в качестве дополнительного – ПЦР; q бактериологические методы и биопробы могут выполняться только специализированными лабораториями

Микробиологическая диагностика Серодиагностика: q развернутая реакция агглютинации (р-я Видаля, р-я Райта); q РПГА; q РСК на холоду; q РИФ; q ИФА Обязательное исследование парных сывороток крови.

Микробиологическая диагностика Аллергодиагностика: проба с тулярином естественного и вакцинального иммунитета. - для оценки q ГЗТ развивается на первой неделе болезни, а также после вакцинации и сохраняется несколько лет (иммунитет не более 5 лет); q у больных туляриновые пробы не рекомендуются в связи с возможностью ухудшения состояния больного; q применяют аллергодиагностику лейкоцитолиза; in vitro - реакция q на 10 день заболевания ставят кровяно-капельную пробу (капля из пальца + капля тулярина, как диагностикум); q если реакция (+) в первые 3 -5 сек, значит титр антител 1: 100 т. е. диагностический, тогда ставят развернутую РА и РГА

Профилактика и лечение q в неблагополучных по туляремии территориях применяют живую туляремийную вакцину; q она обеспечивает прочный иммунитет (проверяется с помощью пробы с тулярином); q с помощью этой пробы отбирают контингенты на вакцинацию и ревакцинацию; q по эпид. показаниям, и лицам, из группы риска (охотники, с/х работники и др. ) применяют вакцину Гайского. Эльберта – накожно; q лечение – антибиотики тетрациклинового ряда стептомицинового и

Бруцеллёз Инфекционное заболевание, характеризующееся длительным течением, лихорадкой, поражением опорно-двигательного аппарата, нервной и др. систем

Возбудители бруцеллёза q род Brucella; 6 видов: B. melitensis (козье-овечий), B. abortus (коровий), B. suis (свиной), B. neotomae (кустарниковых крыс), B. ovis (бараний), B. canis (собачий); q обнаружены англ. бактериологом Дэвидом Брюсом в 1886 г. из селезёнки умершего человека; q старые названия болезни: болезнь Банга, болезнь Траума, лихорадка Кипра, мальтийская лихорадка, средиземноморская лихорадка, свиной бруцеллёз;

Морфология Род Brucella Гр- мелкие палочки или коккобациллы: q факультативные внутриклеточные паразиты; q окрашиваются анилиновыми красителями; q В. melitensis – кокковидные; q В. abortus и В. suis – палочки; q не имеют спор, жгутиков; q иногда образуют микрокапсулу

Культуральные и б/х свойства q аэробы, Т опт. = 370 С; p. H опт. = 7, 4; q плохо растут на питательных средах, даже на обогащенных средах (печеночных или с 5% крови или сыворотки, глюкозы, глицерина); q в S-форме - колонии бесцветные, мелкие, выпуклые, гладкие, с перламутровым оттенком, в R-форме - шероховатые колонии; q на жидких средах – равномерное помутнение; q ферментируют глюкозу и арабинозу до кислоты; q выделяют Н 2 S, чувствительны к фуксину; Медленный точечный рост с q образуют уреазу, каталазу, бесцветных гладких образованием фосфатазу; колоний с перламутровым оттенком q окисляют аминокислоты

Антигенная структура Общий соматический О-АГ – родоспецифический; видовые – поверхностные М- и А-антигены: q А-АГ – преобладает у B. Abortus, q М-АГ – у В. Melitensis; L-антиген - поверхностный – термолабильный (сходен с Vi – Аг сальмонелл); R-антиген у шероховатых форм

Факторы патогенности q белки наружной мембраны (адгезивность); q эндотоксин (высокая инвазивная активность); q гиалуронидаза; q фибринолизин; q капсула – защита от переваривания; q низкомолекулярные продукты (за счёт них подавляется фагоцитоз); q аллергизирующие субстанции

Эпидемиология q Бруцеллёз – зооноз преимущественно с/х и домашних животных; q путь заражения аэрогенный; – q основной контингент животноводства; алиментарный, больных контактный, – работники q источник - крупный и мелкий рогатый скот, свиньи, реже олени, лошади и др. ; q больные люди не являются источником заражения; q иммунитет – не напряженный, не продолжительный (69 мес. )

Резистентность Brucella q Хорошо температурах; сохраняются при низких q сохраняются в воде и почве – до 5 мес. ; q при Т = 60 0 С погибают через 30 минут; при кипячении погибают; q быстро теряют жизнеспособность под воздействием прямых лучей и дезрастворов

Патогенез q проникают через слизистые поврежденную кожу; оболочки или q по лимфатическим путям попадают в регионарные лимфоузлы; q размножаются в макрофагах в первые 5 -10 суток; q переживают внутри фагоцитов, выделяя низкомолекулярные факторы, ингибирующие слияние фагосом с лизосомами; q из разрушенных макрофагов попадают в кровоток; q в крови не размножаются


Патогенез Специфические раздражения I фаза – лимфогенный занос и лимфорецепторное раздражение Инкубация (2 -4 нед. ) Острый период III фаза – полиочаговые локализации (формирование метастатических очагов) Повторные Течение болезни II фаза – гематогенный занос (первичная генерализация) и гемососудистые раздражения Первичные Патогенез Развитие сепсиса IV фаза – экзоочаговые обсеменения Рецидивы и обострения (повторная генерализация) и реактивно-аллергические изменения V фаза – конечный метаморфоз: А) рассасывание; Б) фиброз; В) стойкие последствия (цирроз, рубцы) Исход

Клиническая картина Инкубационный период – 2 -4 недели Клинические формы выражаются: длительной лихорадкой, ознобом, потливостью, гепатолиенальным синдромом вовлекаются ССС, мочеполовая, опорно-двигательная и др. системы q может переходить в хроническую форму; q летальность 2%

Микробиологическая диагностика На исследование берут кровь, мочу, костный мозг, грудное молоко (у кормящих), околосуставную жидкость q основной метод – бактериологический; q чаще выделяют гемо - и миелокультуры; q виды бруцелл дифференцируют: - по потребности в CO 2; - по образованию Н 2 S; - росту на средах в присутствии фуксина и тионина

Микробиологическая диагностика Серодиагностика q основной метод агглютинации Райта и развернутая реакция q ускоренные микрометоды на стекле – реакция агглютинации Хеддельсона; q реакция латекс – агглютинации; q реакция Кумбса - для выявления неполных антител с применением антиглобулиновой сыворотки; q РНИФ, РПГА с антигенным эритроцитарным диагностикумом; q ИФА


Микробиологическая диагностика q при отрицательных результатах серодиагностики применяют аллергическую кожную пробу Бюрне с бруцеллином (белковый экстракт культуры); q реакция положительна у 85% к концу 1 мес. заболевания и вакцинированных; q для выделения бруцелл из объектов внешней среды и от животных используют биопробу, для серодиагностики у животных - РСК

Профилактика Специфическая. В очагах бруцеллеза применяют: Ø живую бруцеллезную вакцину ЖБВ (шт. 19); Ø химические вакцины, с низкой реактогенностью Лечение Антибиотикотерапия. Наиболее эффективны левомицетин, тетрациклин, стрептомицин. В тяжелых случаях применяют полусинтетический антибиотик рифампицин (рифадин)

Трагическая судьба актрисы Екатерины Савиновой 28 работ в 27 проектах

Ещё во время съёмок фильма «Приходите завтра» у Екатерины начались серьёзные проблемы со здоровьем, из-за чего съёмки были прерваны на год. У Екатерины это стала центральная нервная система. Как позднее выяснилось, перед съёмками фильма Екатерина подхватила бруцеллёз инфекцию, которая «выбирает» самые уязвимые места и может поразить любой орган. Инфекцию же актриса подхватила в Крыму, когда снималась в фильме "Сельский врач" у Герасимова. Она постоянно покупала на рынке парное молоко, которое очень любила. Врачи долго не могли поставить правильный диагноз.

Андрей Ташков Актер 100 работ в 99 проектах


Санитарно-гигиенические мероприятия

Возбудители ООИ. Туляремия. Бруцеллез..ppt